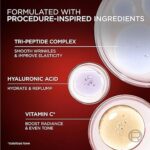
L'Oreal Paris Revitalift Triple Power Age-Defying Face Serum - Image 3

L’Oreal Paris Revitalift Triple Power Age-Defying Face Serum
$21.00
Revitalift Triple Power Age-Defying Serum is a 3-in-1 serum that reduces wrinkles, firms, & brightens. Our formula combines an innovative blend of ingredients for visible, age-defying results: Tri-Peptides (3% Matrixyl 3000): Known to improve the feel of skin’s elasticity, (Argireline Amplified Peptide):
Categories: Loreal, Personal Care
Description
- 3-in-1 Age-Defying Serum for Face: This facial serum visibly reduce wrinkles, firms, and brightens skin. Brightening serum features Tri-Peptides to improve the feel of skin’s elasticity, help smooth the look of wrinkles, and antioxidant properties
- Age-Defying Formula: Hyaluronic Acid hydrates and plumps, while Vitamin C boosts radiance and evens tone. Our Hyaluronic Acid and Vitamin C serum immediately hydrates and smooths and overtime reduces wrinkles, firms, evens tone, and plumps
- For Best Use: Every morning and evening after cleansing, apply 3 to 4 drops of face serum to face and neck. Massage until absorbed. Follow with moisturizer & AM sunscreen. Derm-tested, non-greasy, milky hydrating serum is free of parabens & mineral-oil
- Because You’re Worth It: Find the products your skin needs with our full line of skin care products including moisturizers, serums, cleansers, makeup removers, anti-wrinkle treatments, self-tanners and much more
- L’Oreal Paris Beauty: A leading total beauty care company based in Paris, we offer innovative products and unique expertise from beauty experts in makeup, skin care, hair care, styling and hair color
Reviews (0)
Be the first to review “L’Oreal Paris Revitalift Triple Power Age-Defying Face Serum” Cancel reply
Related products
Eucerin Advanced Repair Body Lotion for Very Dry Skin, Unscented Lotion
$11.00
Fight dryness at its source with Eucerin Advanced Repair Body Lotion. This unscented lotion for dry skin provides 48-hour moisture for skin that looks and feels healthy. Eucerin Advanced Repair Body Lotion for dry skin is formulated with ceramides to help strengthen the skin’s moisture barrier to lock in moisture. It is also formulated with Natural Moisturizing Factors, amino acids that are naturally found in the skin, to boost moisture and help prevent dryness.
Eucerin Original Healing Cream, Unscented Body Cream
$31.00
Eucerin Original Healing Cream is a time-tested formula that helps heal and protect extremely dry, sensitive and compromised skin. This thick, rich body cream for dry skin provides intensive moisture for the skin. Eucerin Original Healing Cream has an emollient-rich formula that binds water to the skin to provide effective moisturization and helps prevent moisture loss by replenishing the skin’s moisture barrier.
Eucerin Radiant Tone Dual Serum Dark Spot Corrector
$29.00
Help visibly reduce the look of persistent dark spots with Eucerin Radiant Tone Dual Serum Dark Spot Corrector. Enriched with Thiamidol, this facial serum helps minimize the look of dark spots due to sun exposure, aging and imperfections. In as little as two weeks skin appears more radiant, and skin clarity continues to improve over time with regular use of this dark spot serum.
L’Oreal Paris Collagen Moisture Filler Moisture Bounce Face Serum
$9.00
Collagen Moisture Bounce Serum is a lightweight, everyday serum that reveals immediately hydrated and more radiant skin. In 1 week, dry fine lines look minimized. In 4 weeks, skin looks plumper and healthier. This serum is formulated with powerhouse moisturizing ingredients for 72H hydration: Collagen that is extracted & purified to help retain its hydrating qualities, Squalene to help nourish skin with moisture, & Glycerin to lock in skin hydration.
Sensodyne Sensitivity & Gum Whitening Toothpaste
$15.00

Reviews
There are no reviews yet.